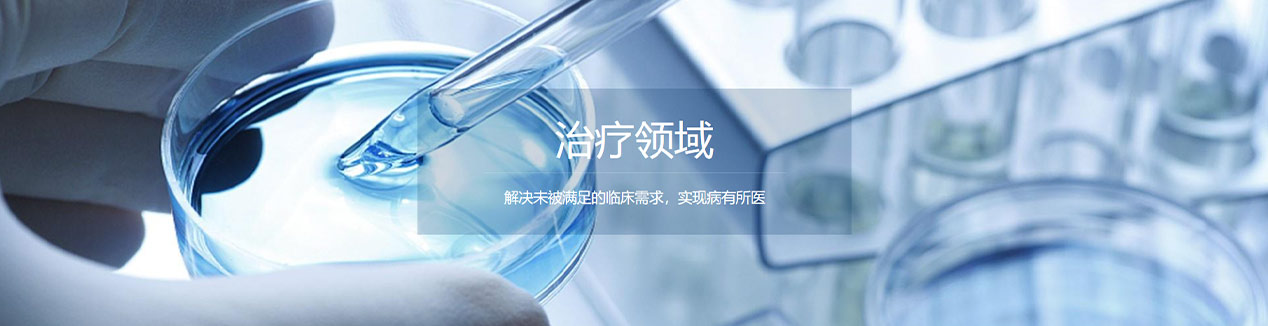
66.jpg

热烈祝贺胜道资本投资企业君实生物科创板成功上市

2020年7月15日,胜道资本投资企业上海君实生物医药科技股份有限公司(以下简称“君实生物”或“公司”)成功在上海证券交易所科创板挂牌上市,股票代码:688180。君实生物本次首发新股发行价为55.50元/股,上市首日收盘价151元/股,股价大涨172.07%。君实生物是胜道资本投资组合中2020年第3家成功上市的企业(耐普矿机2020年2月12日创业板上市,联赢激光2020年6月6月22日科创板上市)。胜道资本本次投资君实生物的主体为旗下管理的陆水河二期基金。
君实生物是一家创新驱动型生物制药公司,以开发治疗性抗体为主,专注于创新单克隆抗体药物和其他治疗性蛋白药物的研发与产业化。公司核心产品之一 JS001 (特瑞普利单抗,重组人源化抗 PD-1单克隆抗体注射液,商品名:拓益)已获批上市,用于治疗既往标准治疗失败后的局部进展或转移性黑色素瘤,目前正在开展适应症拓展的临床试验,UBP1211(修美乐生物类似药)已提交 NDA 并获受理,JS002(重组人源化抗 PCSK9单抗注射液)正在开展临床 II 期试验。
公司产品覆盖肿瘤免疫治疗、代谢类疾病、炎症或自身免疫性疾病、神经系统疾病及抗病毒等领域。具有丰富的在研产品管线。公司共有21项在研产品,13项是由公司自主研发的原创新药,8项与合作伙伴共同开发。雄厚的研发实力及丰富的在研项目储备为公司未来的持续发展壮大奠定了坚实的基础。
君实生物目前在肿瘤免疫疗法、自身免疫性疾病及代谢疾病治疗方面处于行业领先地位,是第一家获得抗PD-1单克隆抗体NMPA上市批准的中国公司,也是国内首家就抗PCSK9单克隆抗体和抗BLyS单克隆抗体取得NMPA的IND申请批准的中国公司。君实生物旨在通过源头创新来开发首创(First-in-class)或同类最优(Best-in-class)的药物,并成为转化医学领域的先锋。随着产品管线的丰富及对药物联合治疗的探索,预计君实生物的创新领域将扩展至包括小分子药物和抗体药物偶联物(或ADCs)等更多类型的药物研发,以及对癌症和自身免疫性疾病下一代创新疗法的探索。

胜道资本高度重视生物医药类企业的发展和投资。胜道资本在投资研究时发现中国生物类似药市场潜力巨大,例如君实生物的PD-1单抗,属于肿瘤治疗领域中的免疫检验点单抗,是当前肿瘤免疫治疗中单抗类药品的研发热点,被认为是继手术、放疗、化疗、靶向治疗后第五大肿瘤治疗技术。且君实生物的PD-1产品正陆续商业化,上市或将迅速抢占市场份额,创造巨大的商业价值。 由此,考虑到君实生物所处行业壁垒高,行业发展前景广阔,同时公司在前沿领域储备了多项在研产品,后续发展潜力巨大,我们判断君实生物有机会获得科创板助推,极具投资价值。
胜道资本所投资企业中除联赢激光、君实生物已成功上市外,后续还有若干家企业有望陆续登录科创板。胜道资本判断硬科技将是资本市场的最新驱动力,相信中国经济即将迎来科技造富时代。我们对中国经济充满信心,疫情不会改变中国经济长期向好的基本面,中国资本市场将迎来蓬勃发展的良好机遇。未来胜道资本将紧跟光电芯片、人工智能、航空航天、生物技术、信息技术等硬科技领域的发展趋势,深度挖掘行业空间和企业潜力,积极把握相应投资机遇,继续助力高成长型科技企业的发展。




 首页
首页 股权投资
股权投资 电话咨询
电话咨询 春笋创孵
春笋创孵






